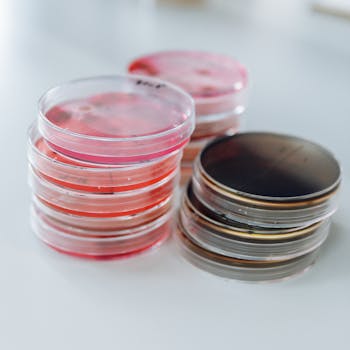
Photo by Charles Deluvio

Started as Eversoft Technologies LLC, we have now expanded into the pharmaceutical and scientific industry, providing trusted products and innovative solutions.
Veeha Scientific and Pharmaceuticals partners with leading manufacturers to offer a wide array of high-quality products across scientific, pharmaceutical, microbiology, and biotechnology industries. We ensure customer satisfaction through tailored solutions and superior quality.
To be a trusted global leader in delivering quality pharmaceuticals and scientific instruments, empowering advancements in healthcare and innovation.
To deliver superior pharmaceutical, microbiology, and biotechnology products with integrity, reliability, innovation, and sustainable, long-term, mutually beneficial partnerships.
We provide exceptional value with a customer-focused approach, providing top-quality products and instruments to meet businesses' evolving needs.
.jpg)
.jpg)
 (1).jpg)

.webp)

.jpg)

With extensive expertise in pharma and scientific instruments, we ensure quality, reliability, and customer satisfaction.
Our supplies are tailored to your needs.
We go beyond expectations in delivering excellence.
Partner with us to achieve your goals seamlessly.
CONNECT WITH US


We hope you have found an answer to your question. If you need any help, Feel free to contact us.
To change your billing information, please follow these steps:
To cancel your account, please follow these steps:
